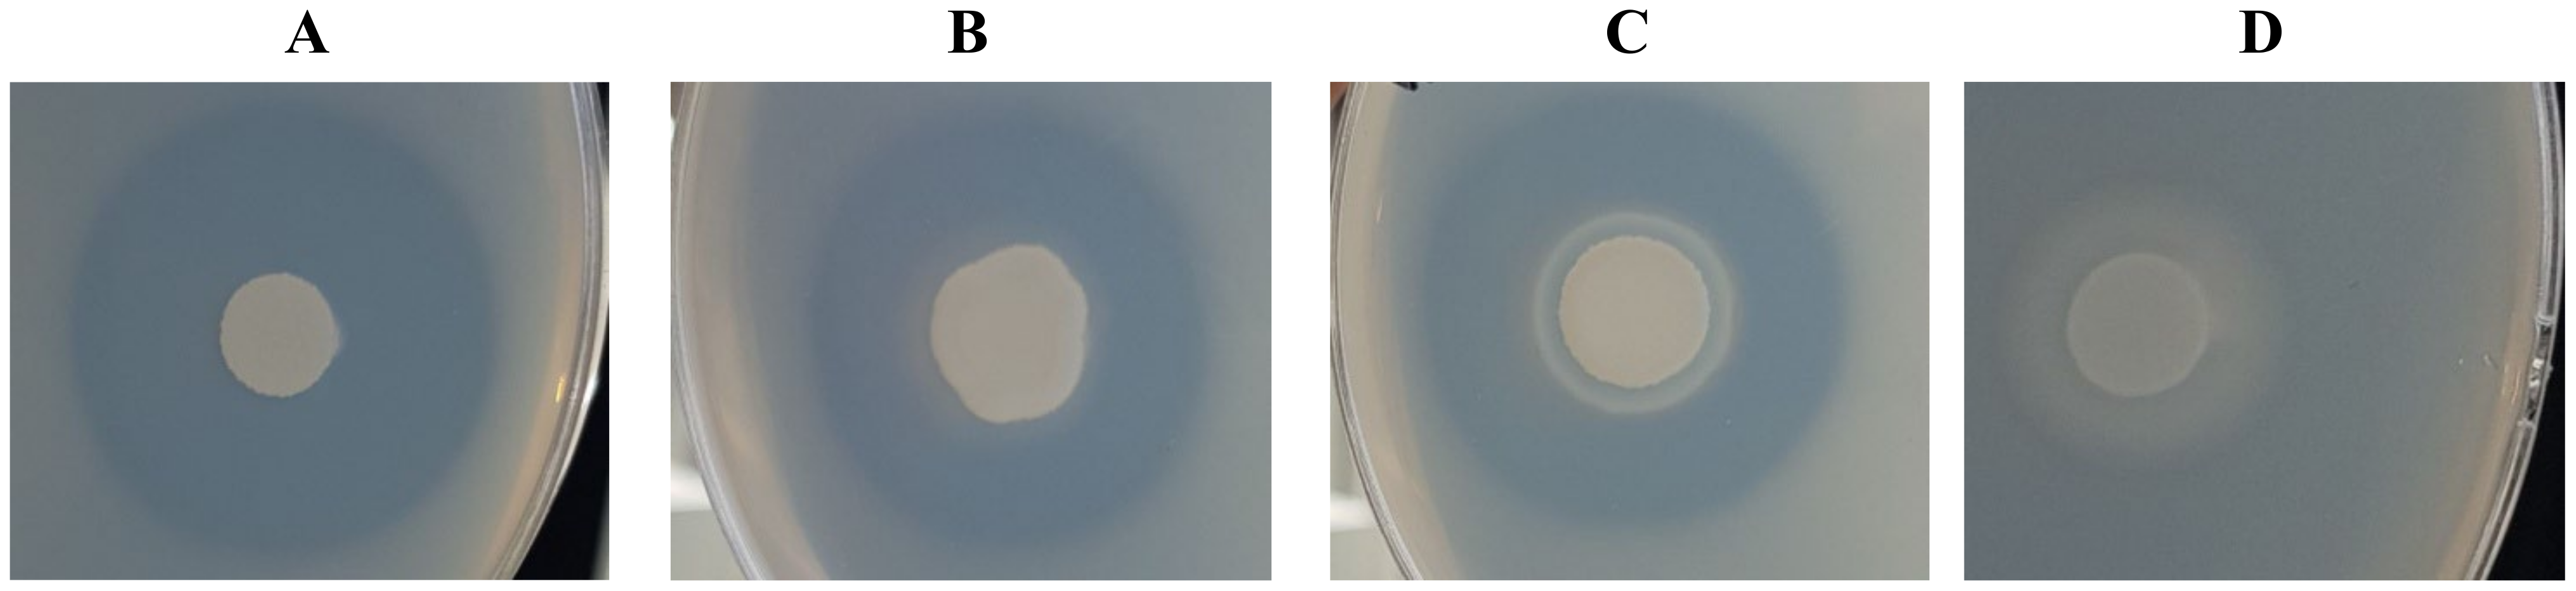
Ijms 24 06514 g004

Comparative Analysis of the Alkaline Proteolytic Enzymes of Yarrowia Clade Species and Their Putative Applications
Abstract
1. Introduction
2. Results and Discussion
2.1. Comparative Analysis of Yarrowia Alkaline Proteases from a Genomic Point of View
2.2. Expression Analysis of Y. lipolytica W29 Alkaline Proteases in Various Culture Conditions and Signal Peptide Prediction
2.3. Analysis of Expression of XPR2Alkaline Protease in the BSG Medium by Y. lipolytica
2.4. Investigation of the Proteolytic Activity of Yarrowia Clade Species
2.5. Characterization of the Proteolytic Activity of Yarrowia Clade Growing on BSG
2.6. Profile of Yarrowia Clade Proteolytic Enzymes Secreted in BSG-Based Medium
2.7. Protein Sequence Coverage of Yarrowia Clade Proteases to Other Fungal Enzymes
2.8. Antioxidant Activity of BSG Protein Hydrolysates
3. Materials and Methods
3.1. Chemicals, Microorganisms, and Materials
3.2. Bioinformatic Analysis of Yarrowia Clade Proteolytic Enzymes
3.3. Analysis of Alkaline Proteases Expression in Y. lipolytica Grown in Various Culture Conditions and Prediction of Putative Signal Peptide
3.4. Analysis of Alkaline Proteases Expression in Y. lipolytica Grown on Spent Grains
3.5. Cultivation of Yarrowia Clade Species in the BSG Medium
3.6. Determination of Hydrolysis Efficiency
3.7. Analysis of the Proteolytic Activity
3.8. Estimation of Proteolytic Enzyme Profiles
3.8.1. Determination of the Profile and Molecular Mass of Yarrowia Clade Proteases Using Gelatin Zymography and Electrophoresis
3.8.2. Comparative Proteomic Analysis of the Yarrowia Clade Proteolytic Enzymes
3.9. Estimation of Antioxidant Activity of BSG Protein Hydrolysates
4. Conclusions
Supplementary Materials
Author Contributions
Funding
Institutional Review Board Statement
Informed Consent Statement
Data Availability Statement
Conflicts of Interest
References
- Van der Walt, J.P.; von Arx, J.A. The yeast genus Yarrowia gen. nov. Antonie Van Leeuwenhoek 1980, 46, 517–521. [Google Scholar] [CrossRef]
- Sugita, T.; Takashima, M. Yeasts, A Taxonomic Study. Med. Mycol. J. 2011, 52, 927–929. [Google Scholar] [CrossRef]
- Péter, G.; Dlauchy, D.; Vasdinyei, R.; Tornai-Lehoczki, J.; Deák, T. Candida galli sp. nov., a new yeast from poultry. Antonie van Leeuwenhoek 2004, 86, 105–110. [Google Scholar] [CrossRef] [PubMed]
- Kurtzman, C.P. New species and a new combination in the Hyphopichia and Yarrowia yeast clades. Antonie van Leeuwenhoek Int. J. Gen. Mol. Microbiol. 2005, 88, 121–130. [Google Scholar] [CrossRef]
- Péter, G.; Nagy, E.S.; Dlauchy, D. Systematics, diversity and ecology of the genus Yarrowia and the methanol-assimilating yeasts. In Non-Conventional Yeasts: From Basic Research to Application; Springer: Berlin/Heidelberg, Germany, 2019; pp. 297–339. [Google Scholar] [CrossRef]
- Quarterman, J.; Slininger, P.J.; Kurtzman, C.P.; Thompson, S.R.; Dien, B.S. A survey of yeast from the Yarrowia clade for lipid production in dilute acid pretreated lignocellulosic biomass hydrolysate. Appl. Microbiol. Biotechnol. 2017, 101, 3319–3334. [Google Scholar] [CrossRef] [PubMed]
- Michely, S.; Gaillardin, C.; Nicaud, J.M.; Neuvéglise, C. Comparative Physiology of Oleaginous Species from the Yarrowia Clade. PLoS ONE 2013, 8, e63356. [Google Scholar] [CrossRef]
- Madzak, C. Yarrowia lipolytica strains and their biotechnological applications: How natural biodiversity and metabolic engineering could contribute to cell factories improvement. J. Fungi 2021, 7, 548. [Google Scholar] [CrossRef]
- Groenewald, M.; Boekhout, T.; Neuvéglise, C.; Gaillardin, C.; Van Dijck, P.W.M.; Wyss, M. Yarrowia lipolytica: Safety assessment of an oleaginous yeast with a great industrial potential. Crit. Rev. Microbiol. 2014, 40, 187–206. [Google Scholar] [CrossRef] [PubMed]
- Park, Y.K.; Ledesma-Amaro, R. What makes Yarrowia lipolytica well suited for industry? Trends Biotechnol. 2022, 41, 242–254. [Google Scholar] [CrossRef]
- Liu, H.H.; Ji, X.J.; Huang, H. Biotechnological applications of Yarrowia lipolytica: Past, present and future. Biotechnol. Adv. 2015, 33, 1522–1546. [Google Scholar] [CrossRef] [PubMed]
- Zinjarde, S.S. Food-related applications of Yarrowia lipolytica. Food Chem. 2014, 152, 1–10. [Google Scholar] [CrossRef]
- Glover, D.J.; McEwen, R.K.; Thomas, C.R.; Young, T.W. pH-regulated expression of the acid and alkaline extracellular proteases of Yarrowia lipolytica. Microbiology 1997, 143, 3045–3054. [Google Scholar] [CrossRef]
- Ogrydziak, D.M.; Demain, A.L.; Tannenbaum, S.R. Regulation of extracellular protease production in Candida lipolytica. BBA Gen. Subj. 1977, 497, 525–538. [Google Scholar] [CrossRef] [PubMed]
- Matoba, S.; Ogrydziak, D.M. A novel location for dipeptidyl aminopeptidase processing sites in the alkaline extracellular protease of Yarrowia lipolytica. J. Biol. Chem. 1989, 264, 6037–6043. [Google Scholar] [CrossRef] [PubMed]
- Enderlin, C.S.; Ogrydziak, D.M. Cloning, nucleotide sequence and functions of XPR6, which codes for a dibasic processing endoprotease from the yeast Yarrowia lipolytica. Yeast 1994, 10, 67–79. [Google Scholar] [CrossRef]
- Ogrydziak, D.M. Yeast extracellular proteases. Crit. Rev. Biotechnol. 1993, 13, 1–55. [Google Scholar] [CrossRef] [PubMed]
- Akpınar, O.; Uçar, F.; Yalçın, H.T. Screening and regulation of alkaline extracellular protease and ribonuclease production of Yarrowia lipolytica strains isolated and identified from different cheeses in Turkey. Ann. Microbiol. 2011, 61, 907–915. [Google Scholar] [CrossRef]
- Yamada, T.; Ogrydziak, D.M. Extracellular acid proteases produced by Saccharomycopsis lipolytica. J. Bacteriol. 1983, 154, 23–31. [Google Scholar] [CrossRef]
- Young, T.W.; Wadeson, A.; Glover, D.J.; Quincey, R.V.; Butlin, M.J.; Kamei, E.A. The extracellular acid protease gene of Yarrowia lipolytica: Sequence and pH-regulated transcription. Microbiology 1996, 142, 2913–2921. [Google Scholar] [CrossRef]
- Rakicka-Pustułka, M.; Miedzianka, J.; Jama, D.; Kawalec, S.; Liman, K.; Janek, T.; Skaradziński, G.; Rymowicz, W.; Lazar, Z. High value-added products derived from crude glycerol via microbial fermentation using Yarrowia clade yeast. Microb. Cell Fact. 2021, 20, 1–18. [Google Scholar] [CrossRef]
- Rakicka, M.; Kieroń, A.; Hapeta, P.; Neuvéglise, C.; Lazar, Z. Sweet and sour potential of yeast from the Yarrowia clade. Biomass Bioenergy 2016, 92, 48–54. [Google Scholar] [CrossRef]
- Ozturk, I. Presence, changes and technological properties of yeast species during processing of pastirma, a Turkish dry-cured meat product. Food Control. 2015, 50, 76–84. [Google Scholar] [CrossRef]
- Joo, H.S.; Kumar, C.G.; Park, G.C.; Paik, S.R.; Chang, C.S. Oxidant and SDS-stable alkaline protease from Bacillus clausii I-52: Production and some properties. J. Appl. Microbiol. 2003, 95, 267–272. [Google Scholar] [CrossRef] [PubMed]
- Lynch, K.M.; Steffen, E.J.; Arendt, E.K. Brewers’ spent grain: A review with an emphasis on food and health. J. Inst. Brew. 2016, 122, 553–568. [Google Scholar] [CrossRef]
- Meunchan, M.; Michely, S.; Devillers, H.; Nicaud, J.M.; Marty, A.; Neuvéglise, C. Comprehensive analysis of a yeast lipase family in the Yarrowia clade. PLoS ONE 2015, 10, e63356. [Google Scholar] [CrossRef]
- Śnieżewski, Ł.; Walczak, E.; Lazar, Z.; Robak, M. Low peptone dose as inductor of alkaline protease promoter used for invertase gene expression in Yarrowia lipolytica. J. Life Sci. 2012, 6, 1100–1108. [Google Scholar]
- Ozturkoglu-Budak, S.; Wiebenga, A.; Bron, P.A.; de Vries, R.P. Protease and lipase activities of fungal and bacterial strains derived from an artisanal raw ewe’s milk cheese. Int. J. Food Microbiol. 2016, 237, 17–27. [Google Scholar] [CrossRef] [PubMed]
- Gardini, F.; Tofalo, R.; Belletti, N.; Iucci, L.; Suzzi, G.; Torriani, S.; Guerzoni, M.E.; Lanciotti, R. Characterization of yeasts involved in the ripening of Pecorino Crotonese cheese. Food Microbiol. 2006, 23, 641–648. [Google Scholar] [CrossRef] [PubMed]
- Atanassova, M.R.; Fernández-Otero, C.; Rodríguez-Alonso, P.; Fernández-No, I.C.; Garabal, J.I.; Centeno, J.A. Characterization of yeasts isolated from artisanal short-ripened cows’ cheeses produced in Galicia (NW Spain). Food Microbiol. 2016, 53, 172–181. [Google Scholar] [CrossRef] [PubMed]
- Braga, A.; Gomes, N.; Belo, I. Lipase induction in Yarrowia lipolytica for castor oil hydrolysis and its effect on γ-decalactone production. JAOCS J. Am. Oil Chem. Soc. 2012, 89, 1041–1047. [Google Scholar] [CrossRef]
- Ciurko, D.; Łaba, W.; Żarowska, B.; Janek, T. Enzymatic hydrolysis using bacterial cultures as a novel method for obtaining antioxidant peptides from brewers’ spent grain. RSC Adv. 2021, 11, 4688–4700. [Google Scholar] [CrossRef] [PubMed]
- Suzzi, G.; Lanorte, M.T.; Galgano, F.; Andrighetto, C.; Lombardi, A.; Lanciotti, R.; Guerzoni, M.E. Proteolytic, lipolytic and molecular characterisation of Yarrowia lipolytica isolated from cheese. Int. J. Food Microbiol. 2001, 69, 69–77. [Google Scholar] [CrossRef]
- Ibarruri, J.; Cebrián, M.; Hernández, I. Solid State Fermentation of Brewer’s Spent Grain Using Rhizopus sp. to Enhance Nutritional Value. Waste Biomass Valorization 2019, 10, 3687–3700. [Google Scholar] [CrossRef]
- Bessadok, B.; Masri, M.; Breuck, T.; Sadok, S. Characterization of the Crude Alkaline Extracellular Protease of Yarrowia lipolytica YlTun15. J. Fish. 2017, 11, 19–24. [Google Scholar] [CrossRef]
- Hernández-Martínez, R.; Sancho-Solano, A.; Loera-Corral, O.; Rojo-Domínguez, A.; Regalado-González, C.; Huerta-Ochoa, S.; Prado-Barragán, L.A. Purification and characterization of a thermostable alkaline protease produced by Yarrowia lipolytica. Rev. Mex. Ing. Quim. 2011, 10, 333–341. [Google Scholar]
- Gasmi, N.; Ayed, A.; Nicaud, J.M.; Kallel, H. Design of an efficient medium for heterologous protein production in Yarrowia lipolytica: Case of human interferon alpha 2b. Microb. Cell Fact. 2011, 10, 38. [Google Scholar] [CrossRef]
- Hernández-Montañez, Z.; Araujo-Osorio, J.; Noriega-Reyes, Y.; Chávez-Camarillo, G.; Villa-Tanaca, L. The intracellular proteolytic system of Yarrowia lipolytica and characterization of an aminopeptidase. FEMS Microbiol. Lett. 2007, 268, 178–186. [Google Scholar] [CrossRef] [PubMed]
- Del Río, J.C.; Prinsen, P.; Gutiérrez, A. Chemical composition of lipids in brewer’s spent grain: A promising source of valuable phytochemicals. J. Cereal Sci. 2013, 58, 248–254. [Google Scholar] [CrossRef]
- Verni, M.; Pontonio, E.; Krona, A.; Jacob, S.; Pinto, D.; Rinaldi, F.; Verardo, V.; Díaz-de-Cerio, E.; Coda, R.; Rizzello, C.G. Bioprocessing of Brewers’ Spent Grain Enhances Its Antioxidant Activity: Characterization of Phenolic Compounds and Bioactive Peptides. Front. Microbiol. 2020, 11, 1831. [Google Scholar] [CrossRef]
- Eszterbauer, E.; Németh, Á. Optimization of Erythritol Fermentation by High-Throughput Screening Assays. Hung. J. Ind. Chem. 2022, 50, 7–10. [Google Scholar] [CrossRef]
- Den Hartog, G.J.M.; Boots, A.W.; Adam-Perrot, A.; Brouns, F.; Verkooijen, I.W.C.M.; Weseler, A.R.; Haenen, G.R.M.M.; Bast, A. Erythritol is a sweet antioxidant. Nutrition 2010, 26, 449–458. [Google Scholar] [CrossRef]
- Wołosiak, R.; Drużyńska, B.; Derewiaka, D.; Piecyk, M.; Majewska, E.; Ciecierska, M.; Worobiej, E.; Pakosz, P. Verification of the conditions for determination of antioxidant activity by abts and dpph assays—A practical approach. Molecules 2022, 27, 50. [Google Scholar] [CrossRef] [PubMed]
- Vieira, E.F.; da Silva, D.D.; Carmo, H.; Ferreira, I.M.P.L.V.O. Protective ability against oxidative stress of brewers’ spent grain protein hydrolysates. Food Chem. 2017, 228, 602–609. [Google Scholar] [CrossRef] [PubMed]
- Sila, A.; Bougatef, A. Antioxidant peptides from marine by-products: Isolation, identification and application in food systems. A review. J. Funct. Foods 2016, 21, 10–26. [Google Scholar] [CrossRef]
- Danquah, M.; Agyei, D. Pharmaceutical applications of bioactive peptides. OA Biotechnol. 2012, 1, 5. [Google Scholar] [CrossRef]
- Fields, K.; Falla, T.J.; Rodan, K.; Bush, L. Bioactive peptides: Signaling the future. J. Cosmet. Dermatol. 2009, 8, 8–13. [Google Scholar] [CrossRef]
- Červenák, F.; Juríková, K.; Devillers, H.; Kaffe, B.; Khatib, A.; Bonnell, E.; Sopkovičová, M.; Wellinger, R.J.; Nosek, J.; Tzfati, Y.; et al. Identification of telomerase RNAs in species of the Yarrowia clade provides insights into the co-evolution of telomerase, telomeric repeats and telomere-binding proteins. Sci. Rep. 2019, 9, 13365. [Google Scholar] [CrossRef]
- Dineen, S.A.; Gibson, D.; Karplus, T.J.; Li, K.; Lopez, W.; McWilliam, R.; Remmert, H.; Söding, M.; Thompson, J.; Higgins, J.D.; et al. Fast, scalable generation of high-quality protein multiple sequence alignments using Clustal Omega. Mol. Syst. Biol. 2011, 7, 539. [Google Scholar]
- Gouy, M.; Guindon, S.; Gascuel, O. Sea view version 4: A multiplatform graphical user interface for sequence alignment and phylogenetic tree building. Mol. Biol. Evol. 2010, 27, 221–224. [Google Scholar] [CrossRef]
- Castresana, J. Selection of conserved blocks from multiple alignments for their use in phylogenetic analysis. Mol. Biol. Evol. 2000, 17, 540–552. [Google Scholar] [CrossRef]
- Guindon, S.; Dufayard, J.F.; Lefort, V.; Anisimova, M.; Hordijk, W.; Gascuel, O. New algorithms and methods to estimate maximum-likelihood phylogenies: Assessing the performance of PhyML 3.0. Syst. Biol. 2010, 59, 307–321. [Google Scholar] [CrossRef]
- Carver, T.; Harris, S.R.; Berriman, M.; Parkhill, J.; McQuillan, J.A. Artemis: An integrated platform for visualization and analysis of high-throughput sequence-based experimental data. Bioinformatics 2012, 28, 464–469. [Google Scholar] [CrossRef] [PubMed]
- Armenteros, J.J.A.; Tsirigos, K.D.; Sønderby, C.K.; Petersen, T.N.; Winther, O.; Brunak, S.; von Heijne, G.; Nielsen, H. SignalP 5.0 improves signal peptide predictions using deep neural networks. Nat. Biotechnol. 2019, 37, 420–423. [Google Scholar] [CrossRef] [PubMed]
- Thumuluri, V.; Armenteros, J.J.A.; Johansen, A.R.; Nielsen, H.; Winther, O. DeepLoc 2.0: Multi-label subcellular localization prediction using protein language models. Nucleic Acids Res. 2022, 50, W228–W234. [Google Scholar] [CrossRef] [PubMed]
- Sun, S.W.; Lin, Y.C.; Weng, Y.M.; Chen, M.J. Efficiency improvements on ninhydrin method for amino acid quantification. J. Food Compos. Anal. 2006, 19, 112–117. [Google Scholar] [CrossRef]
- Anson, M.L. The estimation of pepsin, trypsin, papain, and cathepsin with hemoglobin. J. Gen. Physiol. 1938, 22, 79–89. [Google Scholar] [CrossRef]
- Ciurko, D.; Czyżnikowska, Z.; Kancelista, A.; Łaba, W.; Janek, T. Sustainable Production of Biosurfactant from Agro-Industrial Oil Wastes by Bacillus subtilis and Its Potential Application as Antioxidant and ACE Inhibitor. Int. J. Mol. Sci. 2022, 23, 10824. [Google Scholar] [CrossRef]
- Walker, J.M.; Kruger, N.J. The Bradford Method for Protein Quantitation. In The Protein Protocols Handbook; Springer: Berlin/Heidelberg, Germany, 2009; pp. 17–24. [Google Scholar] [CrossRef]

| No. | Species and Strain | Number of Alkaline Protease |
|---|---|---|
| 1 | Y. lipolytica A101 | 15 |
| 2 | Y. lipolytica E150 (CLIB 122) | 16 |
| 3 | Y. lipolytica H222 | 16 |
| 4 | Y.alimentaria CBS 10151 | 19 |
| 5 | Y. bubula CBS 12934 | 16 |
| 6 | Y. deformans CBS 2071 | 15 |
| 7 | Y. divulgata CBS 11013 | 15 |
| 8 | Y. galli CBS 9722 | 21 |
| 9 | Y. hollandica CBS 4855 | 15 |
| 10 | Y. keelungensis CBS 11062 | 17 |
| 11 | Y. osloensis CBS 10146 | 19 |
| 12 | Y. phangngaensis CBS 10407 | 5 |
| 13 | Y. porcina CBS 12935 | 19 |
| 14 | Y. yakushimensis CBS 10254 | 15 |
| 15 | C. hispaniensis CBS 9996 | 5 |
| YALI Protease | YNB | Expression YPD | Expression on YPD at pH 4 | Functional Annotation | Signal Peptide with SignalP-5.0 | Signal Peptide with DeepLoc-1.0 | Type of Signal Sequence | ||
|---|---|---|---|---|---|---|---|---|---|
| Rank of Expression OA | Rank of Expression GLU | Rank of Expression TB | |||||||
| YALI0A06435g | 941 | 3795 | 4250 | moderate | low | similar to uniprot|P09232 S. cerevisiae YEL060C (ohnolog of YOR003W) PRB1 protease B, vacuolar | 0.9911 | 0.9966 | pre-pro? |
| YALI0A08360g | 3831 | 3360 | 5852 | low | low | weakly similar to uniprot|P09230 Y. lipolytica XPR2 Alkaline extracellular protease precursor | 0.9894 | 0.999 | pre-pro? |
| YALI0A09262g | 6026 | 6038 | 6189 | low | low | uniprot|F2Z604/Q6H9N6 Y. lipolytica YALI0A09262g AEP2 Alkaline extracellular protease precursor | 0.9858 | 0.9988 | pre-pro? |
| YALI0A10208g | NE | NE | NE | NE | NE | similar to uniprot|P09230 Y. lipolytica XPR2 Alkaline extracellular protease precursor | 0.996 | 0.9989 | |
| YALI0B02794g | 5431 | 5513 | 5001 | low | low | similar to uniprot|P25381 S. cerevisiae YCR045C Probable subtilisin-family protease with a role in the formation of the dityrosine layer of the spore | 0.9983 | 0.9914 | |
| YALI0B16500g | 213 | 308 | 246 | high | high | similar to uniprot|P09232 S. cerevisiae YEL060C (ohnolog of YOR003W) PRB1 protease B, vacuolar | 0.9068 | 0.8928 | pre-pro |
| YALI0B19316g | 6162 | 6181 | 5646 | low | low | similar to uniprot|P09230 Y. lipolytica XPR2 Alkaline extracellular protease precursor | 0.9192 | 0.9999 | pre-pro |
| YALI0B22880g | 5772 | 5794 | 5898 | low | low | similar to uniprot|P09230 Y. lipolytica XPR2 Alkaline extracellular protease precursor | 0.9985 | 0.9992 | pre-pro |
| YALI0B22990g | 5953 | 5838 | 6124 | low | low | weakly similar to uniprot|P09230 Y. lipolytica XPR2 Alkaline extracellular protease precursor | 0.9942 | 0.997 | |
| YALI0C15532g | NE | NE | NE | NE | NE | some similarities with uniprot|P09230 Y. lipolytica XPR2 Alkaline extracellular protease precursor | 0.9897 | 0.6785 | pre-pro |
| YALI0C20691g | 5213 | 5520 | 5477 | low | low | similar to uniprot|P09230 Y. lipolytica XPR2 Alkaline extracellular protease precursor | 0.9912 | 0.9998 | pre-pro |
| YALI0D02981g | 5469 | 5561 | 5850 | low | low | highly similar to uniprot|P09230 Y. lipolytica XPR2 Alkaline extracellular protease precursor | 0.98 | 0.9994 | degenerate pre-pro |
| YALI0E28875g | 5377 | 5182 | 5176 | low | low | similar to uniprot|P09230 Y. lipolytica XPR2 Alkaline extracellular protease precursor | 0.9668 | 0.9995 | |
| YALI0F19646g | 6201 | 6207 | 6117 | NE | NE | weakly similar to uniprot|P58371 Magnaporthe grisea Subtilisin-like proteinase Spm1 precursor | 0.9939 | 0.9997 | degenerate pre-pro |
| YALI0F24453g | 5989 | 6046 | 5675 | low | low | weakly similar to uniprot|P25381 S. cerevisiae YCR045c similarity to serin proteases | 0.9916 | 0.9996 | |
| XPR2 | 5263 | 22 | 5880 | moderate | low | uniprot|P09230 Y. lipolytica Alkaline extracellular protease | 0.9833 | 0.9995 | degenerate pre-pro |
| Tested Species | Control | Y. lipolytica | Y. hollandica | Y. galli | Y. phangngaensis | Y. deformans | Y. keelungensis | Y. porcina |
|---|---|---|---|---|---|---|---|---|
| Proteolytic zone diameter [mm] | - | 14.80 (±0.40) | 8.83 (±0.76) | 11.14 (±1.97) | - | - | 14.02 (±0.04) | 12.90 (±0.86) |
| Tested species | Y. yakushimensis | C. hispaniensis | Y. bubula | Y. osloensis | Y. alimentaria | Y. divulgata | Y. parophonii | Y. brassicae |
| Proteolytic zone diameter [mm] | 15.05 (±0.52) | - | 9.18 (±0.32) | 9.05 (±0.08) | 13.51 (±1.01) | 9.52 (±1.32) | 9.73 (±0.64) | 8.33 (±1.52) |
| Host | Molecular Mass [kDa] | Reference to Figure S2 | |||||||||
|---|---|---|---|---|---|---|---|---|---|---|---|
| 30 | 35 | 37–39 | 40 | 55 | 65 | 100 | 110 | 130 | 180 | ||
| Y. lipolytica | × | × | 9A, lane 3 | ||||||||
| Y. alimentaria | × | × | 9A, lane 6 | ||||||||
| Y. hollandica | × | × | 9C, lane 11 | ||||||||
| Y. divulgata | × | × | 9B, lane 10 | ||||||||
| Y. brassicae | × | × | 9B, lane 8 | ||||||||
| Y. porcina | × | × | 9C, lane 12 | ||||||||
| Y. keelungensis | × | 9A, lane 5 | |||||||||
| Y. galli | × | × | 9A, lane 4 | ||||||||
| Y. parophonii | × | × | 9B, lane 7 | ||||||||
| Y. osloensis | × | × | × | 9C, lane 13 | |||||||
| Y. bubula | × | 9B, lane 9 | |||||||||
| Y. yakushimensis | × | 9C, lane 14 | |||||||||
| No | Gene | Primer Name | Sequence |
|---|---|---|---|
| 1 | YALI0F31889 | qXPR2-F | AATCCAGAAGCTGGACTCTC |
| qXPR2-R | CTCGGGGAGAGACACAATG | ||
| 2 | YALI0A06435 | qA06435-F | TGCTTGGAAGCTGCGATATG |
| qA06435-R | AGGGAGCGTCCAGTTCTTC | ||
| 3 | YALI0A08360 | qA08360-F | CATCTTCAAGGACGGTGTTTC |
| qA08360-R | TGGTGACCAAGTCGGAGAAC | ||
| 4 | YALI0A09262 | qA09262-F | GTATCAAGACCGCCTTTGAC |
| qA09262-R | GTACCCTGGTACACGTTCTG | ||
| 5 | YALI0A10208 | qA10208-F | CCAACAATACTGCAGGAAACG |
| qA10208-R | AAATACGAGCCAGGTGATAGG | ||
| 6 | YALI0B02794 | qB02794-F | CGATCGACTCTGGCATTC |
| qB02794-R | TTCGACAGCGAAATCACCTC | ||
| 7 | YALI0B16500 | qB16500-F | CTCACGAGTTGTGGGTTGAG |
| qB16500-R | GTAGGCAATGTCCTTGTGTC | ||
| 8 | YALI0B19316 | qB19316-F | GGATACCACGGGCTGTTTG |
| qB19316-R | CCGGTTGACCTGGTTATCTC | ||
| 9 | YALI0B22880 | qB22880-F | GTCGACGCGTTCACTGATG |
| qB22880-R | ACTGGAAGTCTCGCTTGTG | ||
| 10 | YALI0B22990 | qB22990-F | CGAGTCTGCTGTTGACATTG |
| qB22990-R | ACCCGAATATTTTGAAGCCATC | ||
| 11 | YALI0C15532 | qC15532-F | AAGGCATCACTGCTGACTTC |
| qC15532-R | GGGAGCTGATCACAGTAGAC | ||
| 12 | YALI0C20691 | qC20691-F | CTGACCTCGACTCTGACATC |
| qC20691-R | AAAGGCATTGAGAGCATGTG | ||
| 13 | YALI0D02981 | qD02981-F | CGAAGAGGACCGGTACATTG |
| qD02981-R | GGTTCACGATGGTGGAGTTG | ||
| 14 | YALI0E28875 | qE28875-F | AGACTCGAGAGGAGCACTAC |
| qE28875-R | CTGTGTCGGCAGAGAACTTG | ||
| 15 | YALI0F19646 | qF19646-F | ACGTCGGAACCTTTTCCAAC |
| qF19646-R | GGGTGTTTCGAGGGTTCTG | ||
| 16 | YALI0F24453 | qF24453-F | TGCGTTCGGCAAGTTTAAAG |
| qF24453-R | GGACAGTTCCAGAGACATCATC | ||
| 17 | YALI0D08272 | qAct1-F | CAGTCCAAGCGAGGTATCC |
| qAct1-R | TCTTCTCTCGGTTGGACTTG | ||
| 18 | YADE0S25e00298g1_1 | qDE-00298-F | TCGCCGGAAAGTTCAACTC |
| qDE-00298-R | TAGGCGTAGCTGCTTGC | ||
| 19 | YADE0S07e01684g1_1 | qDE-Act1-F | GCACCACACCTTCTACAAC |
| qDE-Act1-R | GAGAAACCGGAGTAGATGGG |
Disclaimer/Publisher’s Note: The statements, opinions and data contained in all publications are solely those of the individual author(s) and contributor(s) and not of MDPI and/or the editor(s). MDPI and/or the editor(s) disclaim responsibility for any injury to people or property resulting from any ideas, methods, instructions or products referred to in the content. |
© 2023 by the authors. Licensee MDPI, Basel, Switzerland. This article is an open access article distributed under the terms and conditions of the Creative Commons Attribution (CC BY) license (https://creativecommons.org/licenses/by/4.0/).
Share and Cite
Ciurko, D.; Neuvéglise, C.; Szwechłowicz, M.; Lazar, Z.; Janek, T. Comparative Analysis of the Alkaline Proteolytic Enzymes of Yarrowia Clade Species and Their Putative Applications. Int. J. Mol. Sci. 2023, 24, 6514. https://doi.org/10.3390/ijms24076514
Ciurko D, Neuvéglise C, Szwechłowicz M, Lazar Z, Janek T. Comparative Analysis of the Alkaline Proteolytic Enzymes of Yarrowia Clade Species and Their Putative Applications. International Journal of Molecular Sciences. 2023; 24(7):6514. https://doi.org/10.3390/ijms24076514
Chicago/Turabian StyleCiurko, Dominika, Cécile Neuvéglise, Maciej Szwechłowicz, Zbigniew Lazar, and Tomasz Janek. 2023. "Comparative Analysis of the Alkaline Proteolytic Enzymes of Yarrowia Clade Species and Their Putative Applications" International Journal of Molecular Sciences 24, no. 7: 6514. https://doi.org/10.3390/ijms24076514
APA StyleCiurko, D., Neuvéglise, C., Szwechłowicz, M., Lazar, Z., & Janek, T. (2023). Comparative Analysis of the Alkaline Proteolytic Enzymes of Yarrowia Clade Species and Their Putative Applications. International Journal of Molecular Sciences, 24(7), 6514. https://doi.org/10.3390/ijms24076514

